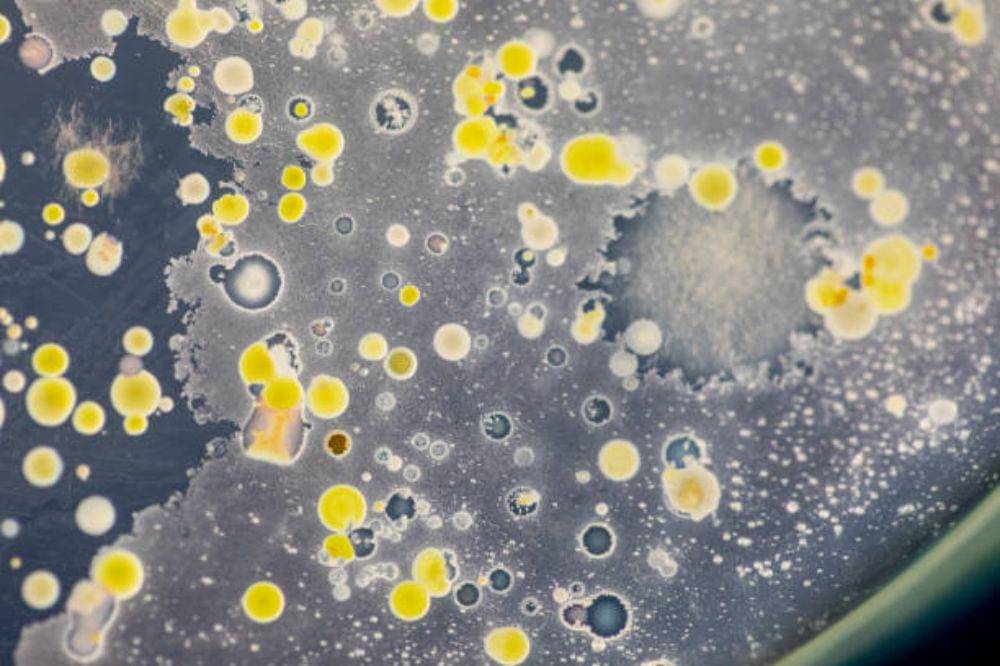
Kuas Make Up Mengandung Banyak Bakteri, Berbahaya bagi Kesehatan

Fakta Kuas Make Up Mengandung Banyak Bakteri, Berbahaya bagi Kesehatan

Kuas make up yang jarang dibersihkan menjadi tempat berkembang biaknya bakteri seperti Staphylococcus aureus, Escherichia coli, dan Enterobacteriaceae.
Bakteri-bakteri ini dapat menyebabkan jerawat, infeksi kulit, iritasi, dan peradangan jika terdapat pada kuas make up yang tidak dibersihkan secara rutin.
Penting untuk membersihkan kuas minimal seminggu sekali dengan sabun lembut atau cairan pembersih khusus serta hindari penyimpanan di ruang lembab seperti kamar mandi.
Kuas make up yang sering digunakan tanpa dibersihkan bisa menjadi tempat berkembang biaknya berbagai jenis bakteri. Meski terkadang suka menyepelekkan, tapi hal ini dapat memicu bahaya untuk kulit wajah.
Kondisi lembab, sisa minyak wajah, dan residu produk kosmetik menciptakan lingkungan ideal bagi mikroorganisme untuk hidup dan menempel pada bulu kuas.
Menurut penelitian dari Aston University, lebih dari 79–90% alat kosmetik yang diuji, termasuk kuas make up, mengandung bakteri seperti Staphylococcus aureus, Escherichia coli, dan Enterobacteriaceae.
Bakteri-bakteri ini bisa menyebabkan berbagai masalah kulit, dari jerawat hingga infeksi yang lebih serius. Maka, sangat penting untuk menjaga dan merawat kuas make up.
Agar Mama lebih paham, Popmama.com telah membahas tentang kuas make up mengandung banyak bakteri, berbahaya bagi kesehatan. Yuk simak penjelasan berikut ini.
1. Staphylococcus aureus

Bakteri ini umum ditemukan di kulit manusia, tetapi bisa menyebabkan infeksi jika masuk ke pori-pori yang terbuka atau luka kecil di wajah. Jika menumpuk pada kuas make up yang jarang dibersihkan, S. aureus bisa memicu jerawat, bisul, bahkan peradangan kulit.
Studi dari Arab Saudi menemukan S. aureus sebagai bakteri dominan di kuas make up yang digunakan berulang kali tanpa disterilkan. Kondisi ini terutama ditemukan pada alat yang disimpan di tempat lembab dan tidak dikeringkan sempurna.
2. Staphylococcus epidermidis

Bakteri ini sebenarnya termasuk flora normal kulit yang berfungsi melindungi tubuh. Namun, jika jumlahnya berlebihan di kuas make up kotor, S. epidermidis bisa memicu iritasi dan peradangan kulit ringan. Jangan biarkan bakteri ini merusak kulit Mama.
Menurut studi mikrobiologi kosmetik, pertumbuhan berlebih bakteri ini sering ditemukan pada alat rias yang tidak pernah dibersihkan lebih dari dua minggu. Ini karena sisa minyak wajah menjadi sumber nutrisi bakteri untuk berkembang biak.
3. Escherichia coli (E. coli)

Biasanya ditemukan di saluran pencernaan manusia, E. coli bisa berpindah ke kuas make up melalui tangan yang tidak bersih. Bakteri ini dapat menyebabkan infeksi kulit dan iritasi jika menempel di wajah.
Para peneliti menemukan bahwa alat make up yang disimpan di kamar mandi lebih berisiko terkontaminasi E. coli akibat percikan air dan kelembapan tinggi. Karena itu, sebaiknya kuas disimpan di tempat kering dan tertutup.
Selalu perhatikan peletakan dan penyimpanan barang-barang Mama di rumah, terutama pada kuas make up yang langsung berhubungan dengan kulit wajah.
4. Bacillus spp. dan Bacillus cereus

Banyak yang mengira iritasi atau munculnya jerawat karena menggunakan produk yang tidak cocok, namun ternayta dibalik itu semua ternyata bisa saja terjadi dari alat make up yang sering Mama gunakan seperti kuas make up.
Bakteri ini dikenal tahan terhadap panas dan dapat bertahan di bulu kuas bahkan setelah dibersihkan secara tidak sempurna. Ia bisa menyebabkan iritasi kulit ringan atau kemerahan pada wajah.
Dalam studi mikrobiologi kosmetik, Bacillus cereus ditemukan pada lebih dari 10% alat make up yang diuji, terutama yang berbahan bulu sintetis. Oleh karena itu, sterilisasi rutin sangat disarankan untuk mencegah pertumbuhan bakteri ini.
5. Pseudomonas aeruginosa
Bakteri ini sangat suka tempat lembab, seperti kuas yang belum kering sempurna setelah dicuci. Infeksi dari Pseudomonas bisa menyebabkan folikulitis atau peradangan pada folikel rambut wajah. Hal ini dapat memunculkan jerawat batu meradang.
Penelitian mikrobiologi kosmetik menunjukkan bahwa Pseudomonas aeruginosa sering ditemukan pada spons dan kuas yang digunakan bergantian. Kondisi ini memperbesar risiko infeksi kulit maupun mata.
6. Candida albicans dan Jamur Lain

Jamur ini bisa tumbuh di kuas yang lembab dan tidak kering sempurna setelah dicuci. Gejalanya antara lain rasa gatal, kemerahan, dan kulit bersisik di area wajah.
Menurut dokter kulit yang dikutip IDN Times, jamur dan bakteri pada kuas kotor sering memicu breakout di area dagu dan pipi. Karenanya, penting untuk mencuci kuas minimal seminggu sekali.
Para ahli menyarankan membersihkan kuas setidaknya seminggu sekali dengan sabun lembut atau cairan pembersih khusus. Setelah dicuci, keringkan di tempat terbuka dan hindari penyimpanan di ruang lembab seperti kamar mandi.
Selain itu, hindari penggunaan kuas bersama orang lain untuk mencegah penularan bakteri. Kebiasaan kecil ini efektif menurunkan risiko jerawat, iritasi, dan infeksi kulit akibat alat rias yang kotor.
Selain itu, Mama juga harus memperhatikan penyimpanan dan disarankan simpan ditempat khusus alat-alat kuas make up.
Nah itulah pembahasan tentang kuas make up mengandung banyak bakteri, berbahaya bagi kesehatan. Semoga setelah membaca artikel ini, Mama bisa lebih terjaga ya.



















